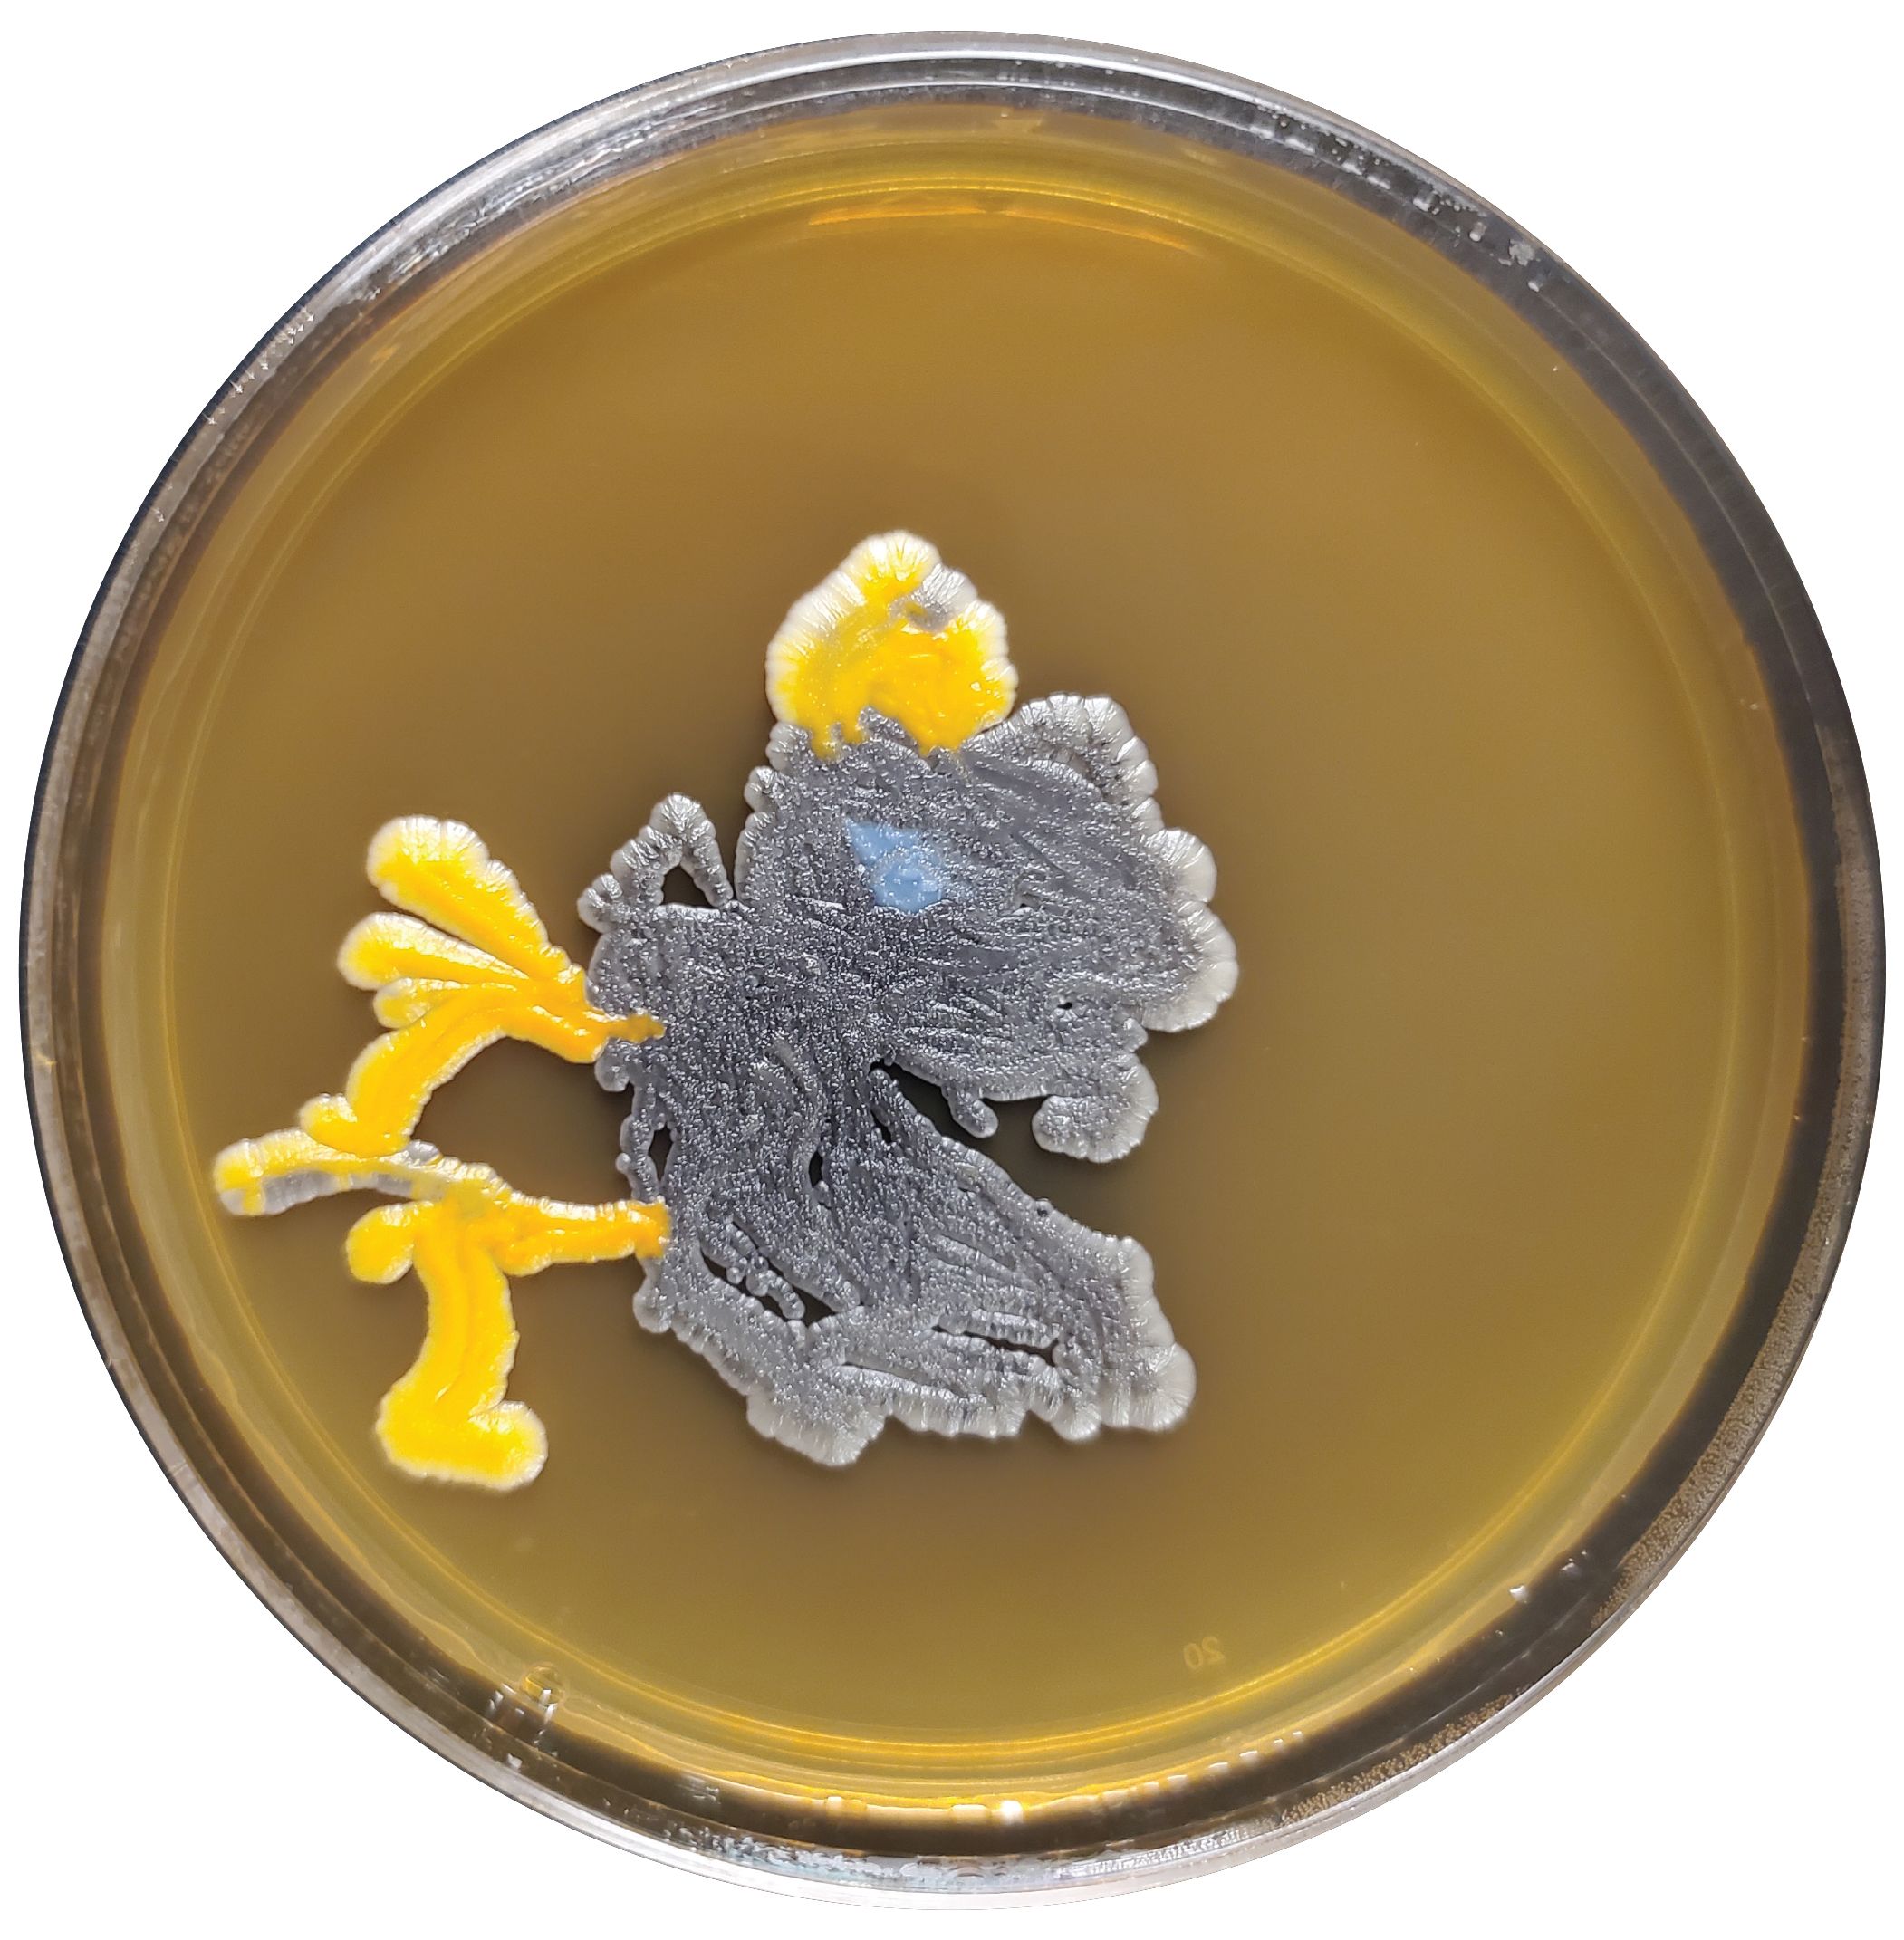

CIPD Festival of Work 2024 | Content +
Read the articles

Exclusive Work. articles
Click the links below and explore the premium content
Work. | Spring 2024, Issue 40
Tony Hsieh
The mysterious death of Zappos founder Tony Hsieh rocked the tech start-up world. So what happened? A case of addiction and poor mental health – or a cautionary tale of happiness as a corporate mission gone wrong?
Work. | Spring 2024, Issue 40
Culture
Is company culture more nebulous, more organically formed, than management gurus and CEOs often have it? And does our ‘how we do things around here’ obsession risks eclipsing stuff HR might actually control?
Work. | Winter 2023, Issue 39
Work allocation
The way we assign tasks today has a critical impact on productivity and morale – and is much more complex than in factories of old. Yet the concept is still hugely underexplored
Work. | Summer 2024, Issue 41
Alison Taylor Q&A
Leaders must avoid treating responsible business as PR and focus on specific, achievable ESG goals, says author and academic Alison Taylor
People Management articles
Click the links below and explore the premium content
AI: how HR can ask (and answer) the right question
Jobseekers have been using artificial intelligence to turn their holiday snaps into professional photos. But that’s just the tip of the iceberg for the technology – which is why the people profession needs to understand the potential, and the limitations, of what’s coming next
The perils of getting your hybrid policy wrong – and how to avoid them
The office vs home working debate isn’t going away – to help you decide on the best approach, People Management spoke to firms making fully remote, office-based and hybrid arrangements work
Expert panel: Is the flurry of new employment laws a burden for HR?
This year sees new regulations affecting – among others – carers and pregnant workers. But they also impact people professionals. Two legal experts and two HR leaders offer their insights

The CIPD work in partnership with Haymarket Media Group Ltd to deliver CIPD Festival of Work
The Chartered Institute of Personnel and Development
151 The Broadway, London SW19 1JQ,
UK Incorporated by Royal Charter,
Registered Charity no. 1079797
Haymarket Media Group
Bridge House, 69 London Road
Twickenham, TW1 3SP
All Rights Reserved.
2025 Event dates
08:30 - 17:30, Wednesday 11 June 2025
08:30 - 16:30, Thursday 12 June 2025
ExCeL London, One Western Gateway,
Royal Victoria Dock, London, E16 1XL
What 3 words: ///cheer. events.began
Contacts
Customer Service: cipdevents.tickets@haymarket.com
Sales & Sponsorship: sales@festivalofwork.com
Marketing & Partnerships: pag.marketing@haymarket.com
Press Office: pag.marketing@haymarket.com